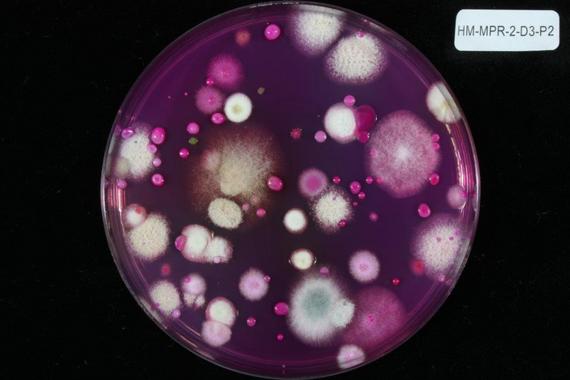

Investigadores de la Universidad de Almería han identificado los factores claves que intervienen en la mejora y el control del compostaje de los residuos vegetales agrícolas.
Expertos del grupo de Investigación Desarrollo de Técnicas Microbiológicas para la Mejora de Suelos de Interés Agrícola de la Universidad de Almería han identificado los factores claves del compostaje de los residuos vegetales agrícolas. Esta técnica se suele utilizar en agricultura para transformar, de forma biológica, todo tipo de restos orgánicos en nutrientes homogéneos y asimilables por las plantas.
En el artículo, publicado en la revista Bioresource Technology, los científicos han descrito los mecanismos implicados en la biodegradación de la materia orgánica, un análisis que permitió determinar los parámetros que contribuyen de forma más eficaz en el proceso de compostaje.
“Hemos identificado cuáles son las etapas críticas y específicas para este tipo de residuos, así como las operaciones más idóneas para cada una de ellas. De esta forma, el control es más preciso, lo que implica tanto una mayor eficacia como la obtención de compost de mayor calidad”, explica la investigadora de la Universidad de Almería María José López.
En primer lugar, el equipo de expertos preparó la cantidad necesaria de residuo vegetal para desarrollar el ensayo de compostaje que tuvo lugar en la provincia de Almería. “El proceso, que se prolongó durante seis meses, se inició en la planta piloto de nuestro grupo de investigación, la cual dispone de controles automatizados de los parámetros más importantes que intervienen como la temperatura, la aireación, etc.”, explica la investigadora. Y añade: “En cada etapa o fase crítica del proceso de biodegradación recogimos diferentes muestras en las que se cuantificaron las bacterias y hongos presentes y se analizó su efecto en la transformación de la materia orgánica, permitiendo de esta forma identificar los factores claves”.
Un sistema sostenible
El presente trabajo aborda un nuevo enfoque en el estudio de los diferentes parámetros que favorecen el compostaje, un proceso que para los investigadores proporciona un material que mejora de las características físicas, químicas y biológicas del suelo.
“El producto obtenido a partir de nuestro estudio resulta valioso desde el punto de vista agronómico, ya que además de favorecer el reciclaje de forma segura los residuos orgánicos generados en agricultura, permite el retorno al propio sistema de un sustrato de elevada calidad como fertilizante”, sostiene López.
De hecho, los resultados obtenidos han permitido al equipo de expertos abrir nuevas líneas de investigación con el objetivo de extender la aplicabilidad de los microorganismos recogidos a partir del compost en diversos procesos industriales, agroalimentarios y ambientales. “Los datos nos permitirán analizar su influencia en áreas como el tratamiento de fibras textiles, la producción de biocombustibles, la biodescontaminación ambiental, el control biológico o la mejora de alimentos, entre otros”, concluye.
Estos resultados son fruto de los proyectos Diseño de programas de inoculación en procesos de compostaje de restos hortícolas y Caracterización de las capacidades biológicas presentes en la microbiota asociada al proceso de compostaje, financiados por el Ministerio de Economía y Competitividad y desarrollados por el Grupo de Investigación Desarrollo de Técnicas Microbiológicas para la Mejora de Suelos de Interés Agrícola del Departamento de Biología y Geología de la Universidad de Almería.
Fuente: SINC.